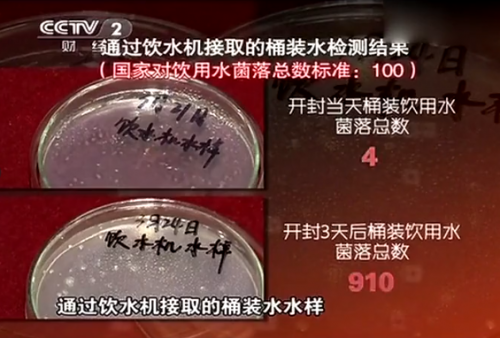

近期,据陆玖财经随机采样的20家北京、南京和成都的水站数据显示,每一个点位的社区桶装水需求,都在呈现10%到15%不等的年递减趋势。此前,网易财经、齐鲁晚报等多家媒体均有过关于桶装水销量减少的报道。桶装水发展遭遇“寒冬”,净水机产品则逆袭而上成为热门,尤其安全、健康、节能的碧水源纳滤净水机正成为人们保障饮水安全健康的主流选择。
桶装水弊端凸显,发展迎“寒冬”
桶装水曾是中国家庭饮用水市场的主角,让家家户户都能喝上相对干净、卫生的水,但随着时间的推移,其存在的诸多弊端开始暴露,尤其2020年,突如其来的新冠疫情让桶装水的发展更是举步维艰。
近年来,偷灌自来水、使用黑心桶等制假售假行为屡禁不止,铜绿假单胞菌等细菌超标现象屡见报端,桶装水市场可谓乱象丛生,饮水安全无从谈起。同时,疫情期间,北京、柳州等地爆出送水工感染新冠病肺炎引发全网热议,无论是周转桶还是送水工,均存在交叉感染风险,为此,北京、吕梁、淄博、昆明等地纷纷对桶装水亮起了“红灯”。

▲图源网络
在使用层面,桶装水还面临无形的健康风险。据CCTV-2央视财经《是真的吗》栏目曝光,经国家计量资质认证的检测机构检测数据显示,生产合格的桶装水开封后3天的菌落总数是开封当天的菌落总数的227倍,超过国家标准8倍。菌落总数超标的水可能会导致人体免疫力下降,特别是对易感人群, 如老人、小孩等, 甚至会出现肠胃不适, 呕吐腹泻等症状, 危害人体健康。
▲图源网络
桶装水不安全、不健康的弊端日益凸显,居民饮水安全无法保障,因此,人们开始选择使用净水机来取代桶装水解决日常饮水问题。据《现代家电》分析,至2025年左右桶装水市场空间会逐渐萎缩,净水机将显著增长,成为日常饮水的新选择。
净水机成“新宠”,纳滤技术更符合健康饮水需求
据腾讯网消息,某全国前三的电商平台数据显示,净水品类近三年的销售额复合增长率高达80%以上;特别受疫情影响,销售额同比增长一倍以上。
可见,在健康消费升级的大背景下,人们对于净水设备的需求量大幅提升。对于净水机的选择,清华大学环境学院王占生教授推荐使用纳滤净水机。王教授认为,纳滤净水机能去除水中有害物质,保留有益矿物元素,是既安全又健康的新一代净水设备。
高科技环保企业碧水源作为纳滤技术的先行者,创新研制的纳滤净水机,采用“电荷哨兵”技术,将电荷作用与滤芯孔径控制相结合,从技术上解决了传统净水机“过度过滤”的弊端,既可将水中细菌、病毒、有机污染物、重金属、余氯等有害物质去除,又可保留对人体有益的钾、钠、钙、镁等矿物质。不只保障饮水安全,更注重饮水健康,与当下人们安全健康的饮水需求相吻合。同时,与传统净水机相比,碧水源纳滤净水机运行压力低、通量大,节水省电。

● 安全:去除有害物质,即滤即饮,水质新鲜;
● 健康:选择性过滤,保留矿物元素;
● 智能:远程监测,智能屏显净水效果;
● 经济:比传统净水机节水约3倍;
● 时尚:简约,庄重。
随着桶装水弊端的日益凸显,净水机将成为饮用水市场的主流趋势。碧水源纳滤净水机从根源上解决了桶装水存在的诸多弊端,让人们足不出户喝上安全健康水,是新时期健康饮水的不二之选。
声明:转载目的在于传递更多信息,文章版权归原作者所有,内容为作者个人观点。本站只提供参考并不构成任何投资及应用建议。如涉及作品内容
或其它问题,请在30日内与工作人员联系(附联系方式),我们将第一时间与您协商。谢谢支持!
|

